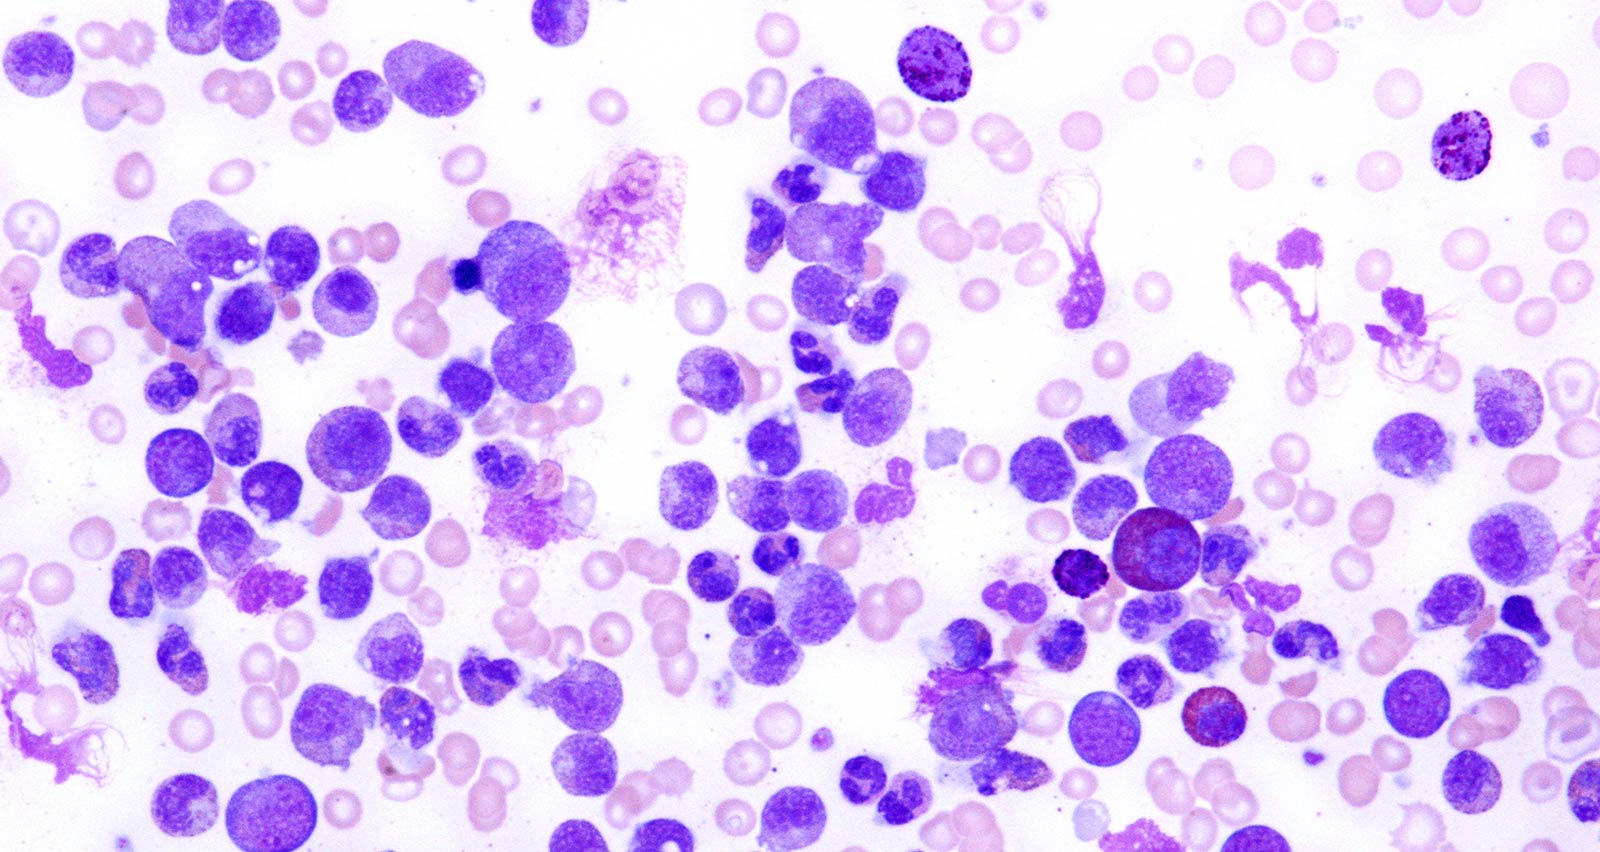
Light micrograph of a blood smear from a patient with chronic myeloid leukemia

What Is Chronic Myeloid Leukemia (CML)?
Leukemias are cancers that start in cells that would normally develop into different types of healthy blood cells. Chronic Myeloid Leukemia (CML) is blood cancer that begins in the blood-forming myeloid cells in the bone marrow. The type of leukemia is also called chronic myelogenous leukemia and chronic granulocytic leukemia.
Relatively uncommon, CML usually affects older adults and seldom occurs in children, but can occur at any age. The cancer is considered “chronic” in that the disease usually progresses at a slower rate than acute forms of leukemia. Modern advances in treatment have made it possible for many people with CML to effectively manage the condition with medication.
Your health is important. Get expert care.
Offering in-person, video and telephone visits. Call 216-844-3951 today to see which option is right for you.
Learn more about virtual visitWhat Causes Chronic Myeloid Leukemia?
CML occurs due to a change (mutation) in certain bone marrow cells. The change is acquired, meaning it’s not present at birth. Doctors don’t yet know what causes the acquired mutation. However, scientists have made much progress in understanding how certain changes in DNA lead to normal bone marrow cells turning into leukemia cells. In CML, this process is better understood than in other leukemias.
Blood cells are produced in the bone marrow, the spongy material inside your larger bones. When bone marrow functions normally, it makes immature cells (blood stem cells) in a controlled manner. These cells mature into various specialized blood cells, including red cells, white cells and platelets.
Most people with CML have an abnormal chromosome in their blood cells called the Philadelphia chromosome. This chromosome leads to the formation of an abnormal gene (BCR-ABL), that disrupts the normal process of blood cell growth by causing abnormal white blood cell to grow out of control. These diseased cells do not die off like normal cells. Instead, they accumulate to crowd out healthy blood cells while damaging the bone marrow.
The risk factors for CML are:
- Age: The risk of getting the disease goes up with age.
- Gender: CML occurs slightly more often in men than women.
- Radiation exposure: Exposure to high-dose radiation increases the risk of getting CML.
Signs and Symptoms of Chronic Myeloid Leukemia
Symptoms of CML may include:
- Weakness
- Fatigue
- Weight loss
- Fever
- Night sweats
- Bone pain as a result of leukemia cells spreading from the marrow cavity to the surface of the bone or into the joints
- Enlarged spleen (which appears as a mass under the left side of the ribcage)
- Pain or a sense of “fullness” in the abdomen
- A feeling of fullness after eating only a small amount of food
Note that other cancers and illnesses can cause the above symptoms. Make sure to tell your doctor about any symptoms of disease you may have.
How Is Chronic Myeloid Leukemia Diagnosed?
Procedures and tests used in the diagnosis of CML include:
- Physical exam: Your doctor will examine you to check your vital signs. They will also feel your lymph nodes, spleen and abdomen to check for any abnormal enlargement. Your doctor will also ask you about your family medical history and your own general health.
- Blood tests: A complete blood count (CBC) with differential test is used to measure the number of white blood cells, red blood cells and platelets in a blood sample. If a CBC test suggests leukemia, a CML diagnosis can sometimes be confirmed with additional blood testing alone, but a bone marrow test is often also needed.
- Bone marrow test (bone marrow aspiration and biopsy): During this test, a needle is used to obtain a bone marrow sample from the breastbone or hipbone. Lab analysis will classify the blood cells in the marrow sample and determine is leukemia cells are present. This test also looks for changes in leukemia cells and identifies whether those cells began as B lymphocytes or T lymphocytes, which assists your provider in developing your treatment.
- Spinal fluid test: Also called a lumbar puncture test or a spinal tap, a spinal fluid test can be used to extract a sample of spinal fluid (the fluid that surrounds the brain and spinal cord) to check for the presence of cancer cells.
- Specialized tests to look for the Philadelphia chromosome: Fluorescence in situ hybridization (FISH) analysis, the polymerase chain reaction (PCR) test and certain other tests are used to analyze blood or bone marrow samples for the presence of the Philadelphia chromosome or the BCR-ABL gene.
- Imaging tests: Imaging tests such as computerized tomography (CT), magnetic resonance imaging (MRI) and ultrasound are used to obtain pictures of structures inside the body. While imaging tests are not needed to diagnose CML, they are sometimes used to look for alternative causes of symptoms or to see if the liver or spleen have become enlarged.
How Is Chronic Myeloid Leukemia Treated?
In treating CML, the goal is to eliminate blood cells that contain the abnormal BCR-ABL gene, which is the cause of the uncontrolled production and accumulation of diseased blood cells. For most patients, treatment starts with targeted drugs that can often help achieve long-term remission of the cancer.
- Targeted Drug Therapy
-
Targeted drugs are usually the first-line treatment for people diagnosed with CML. Targeted drug therapy uses drugs or other substances to identify and attack specific cancer cells. In general, targeted therapies cause less harm to normal cells than chemotherapy or radiation therapy. In CML, the target of these drugs is the protein made by the BCR-ABL gene: tyrosine kinase. Targeted drugs that block the action of tyrosine kinase include:
- Imatinib (Gleevec)
- Dasatinib (Sprycel)
- Nilotinib (Tasigna)
- Bosutinib (Bosulif)
- Ponatinib (Iclusig)
- Asciminib (Scemblix)
During therapy, blood tests are used to detect the presence of the BCR-ABL gene in order to monitor the effectiveness of the therapy. Should the disease not respond well to therapy, doctors may consider using targeted drugs such as omacetaxine (Synribo) or other treatments.
Because experts have not yet determined the safest point at which people with CML should stop taking targeted drugs, most patients continue even after blood tests confirm remission of the disease. You and your doctor may consider stopping target drug therapy after considering the benefits and risks.
- Chemotherapy
-
Chemotherapy is a type of treatment that uses drugs to kill cancer cell. Most often, chemotherapy drugs are injected directly into a vein, a muscle or under the skin, or else taken by mouth. By entering the bloodstream, chemotherapy drugs are able to reach leukemia cells all throughout the body. Chemotherapy drugs are sometimes combined with targeted drug therapy to treat more aggressive cases of CML.
- Bone Marrow Transplant
-
A bone marrow transplant, also known as a stem cell transplant, replaces abnormal bone marrow with marrow from a healthy. The bone marrow transplant is performed after high doses of chemotherapy or radiation are employed to destroy leukemia-producing bone marrow.
The Stem Cell Transplant Program at UH Seidman Cancer Center has provided advanced bone marrow and cord blood transplant services for more than 45 years. Since the program’s inception, we’ve performed over 3,500 stem cell transplants.
Chronic Myeloid Leukemia Prognosis
CML usually takes a long time to progress. A person can have the cancer for years before noticing symptoms. If left untreated, chronic myeloid leukemia can become a life-threatening illness within three to four years after it begins. Treatments for people with CML have improved dramatically over the past 50 years, including introduction of highly effective targeted therapy drugs such as imatinib, dasatinib, nilotinib, and bosutinib.
Today, the ten-year survival rate (the percentage of people who are alive ten years after diagnosis) for the most common form of CML is approximately 85 percent. Survivors can expect to live nearly as long as adults who do not have the disease.

Clinical Trials Available for Chronic Myeloid Leukemia and Other Types of Leukemia
Access to innovative treatments, including leukemia-specific clinical trials with targeted agents, gives patients more treatment options. We offer new therapies that are safer, more tolerable and more targeted to help minimize side effects. Our physicians are the principal investigators for many of these cancer clinical trials, offering hope to both newly diagnosed leukemia patients and those who have relapsed.
Clinical Trials for Leukemia
Giving to UH Seidman
Make a gift today to support leukemia research and patient care at UH Seidman Cancer Center.
Ways To Give

